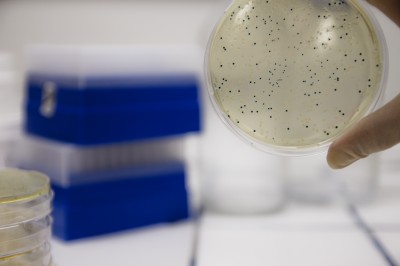

Producenci
Producenci
NZYStar
 Opis
Opis
NZYStar Competent Cells are suitable for general cloning protocols and for the construction of gene banks or the generation of cDNA libraries using plasmid-derived vectors. Tetracycline ensures that the selectable F´ containing lacZα M15 is maintained and thus eliminates the background of non-recombinant white colonies which have lost the F´. NZYStar Competent Cells are lacIq and require IPTG to induce expression from the lac promoter.
Features:
- Transformation efficiency: ≥ 109 cfu/μg of pNZY28
- Blue/White screening capability
Applications:
- Construction of cDNA libraries
- Construction of gene banks
- High quality plasmid preparation
- Mutagenesis
- Routine cloning
Specifications:
- Genotype: endA1 hsdR17(rk-, mk+) supE44 thi -1 recA1 gyrA96 relA1 lac[F´ proA+B+ lacIq ZDM15 :Tn10(TcR)]
- Storage conditions: Store at -80 ºC
- Shipping conditions: Shipped at dry ice
Components:
- NZYStar Competent Cells (10 or 20 × 200 µL)
- Competent Cells Control Plasmid (10 µL at 0.1 ng/µL)
 Dane techniczne
Dane techniczne
| Opakowanie | op. |